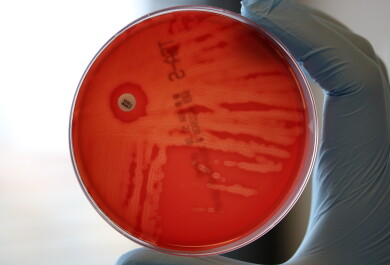

A population-based study led by the University of Turku, Finland, investigated factors associated with the prevalence of antibiotic resistance. In addition to antibiotic use, diet, gender, living environment, income level and certain gut bacteria were associated with a higher burden of resistance. A higher resistance burden was associated with a 40% higher risk of all-cause mortality during the follow-up.
Antibiotic-resistant bacteria cause more than one million deaths per year worldwide, and the number is rising fast.
A recent study shows that an increase in relative mortality risk can be predicted by high resistance burden as well as by elevated blood pressure or type 2 diabetes. The number of antibiotic resistance genes found in gut bacteria predicted the risk of sepsis or death during a long follow-up period of almost two decades.
An international research team collaborated to analyse stool samples from more than 7,000 Finns as part of the FINRISK population-based study. The researchers investigated factors influencing the prevalence of antibiotic resistance genes and their association with sepsis and mortality over 17 years of follow-up.
“Finnish population studies are internationally unique thanks to the national health registers, and for the first time we were able to investigate the association of antibiotic resistance with population health over nearly two decades. The prevalence of antibiotic-resistant bacteria is constantly increasing, and large population studies help us to better understand the role of demographics and lifestyle in mitigating the problem," says Katariina Pärnänen, first author of the study and Academy Research Fellow by the Research Council of Finland.
In addition to antibiotics, diet and social factors linked to higher resistance burden
The single largest factor explaining the number of resistance genes was antibiotic use; it predicted increased resistance even for years ahead. Indeed, the effects of antibiotics on the gut microbiota can be long-lasting.
The most common antibiotic resistance genes were tetracycline resistance genes. The use of tetracyclines had the strongest association with resistance burden of all antibiotics.
In addition, diet and many other factors can be reflected in microbial composition. The study found that certain gut bacteria were strongly associated with resistance burden, particularly Escherichia coli and Bacteroides, which are associated with the western diet. On the other hand, bifidobacteria considered beneficial for health and Prevotella associated with a fibre-rich diet were associated with a lower resistance burden. Fibre-rich foods such as berries, potatoes and rye bread also predicted lower resistance.
Food can also transport antibiotic-resistant bacteria into the body; raw vegetables, salad and chicken, which sometimes contain high levels of resistant bacteria, were associated with a higher resistance burden.
In addition to diet, social factors such as gender, place of residence and income were linked to the resistance burden. Women had systematically higher resistance than men. Living in large cities, densely populated areas and high-income households were also associated with a higher risk.
“The results are interesting because these factors predicting a higher resistance burden are generally associated with better health," Pärnänen explains.
Resistance burden is an important health indicator – predicts the risk of sepsis and death
The study found that a high resistance burden was linked to 40% higher risk of all-cause mortality and more than double the risk of sepsis over 17 years of follow-up. The resistance-related mortality risk was particularly significant for deaths related to respiratory infections. The study does not show a causality, but it shows that the resistance burden could provide an indicator of general health status.
Scientific computing plays a key role in analysing the datasets generated by population research and DNA sequencing.
“Our research shows how machine learning and high-performance computing can help to solve public health challenges. The supercomputers managed by the Finnish IT Center for Science (CSC) are among the best in Europe and offer a significant international advantage for our research," says Leo Lahti, Professor of Data Science at the University of Turku, who coordinated the study.
At a population level, reducing antibiotic use is the most effective way to curb the burden of resistance, but the findings suggest that everyone can play their part in reducing the spread and impact of resistance.
“Prevention of infections, good hand hygiene, food hygiene and a balanced diet support gut health. By paying attention to these, everyone can help prevent the spread of antibiotic resistance," says Pärnänen.
The study was published in Nature Communications on 1 July 2025.